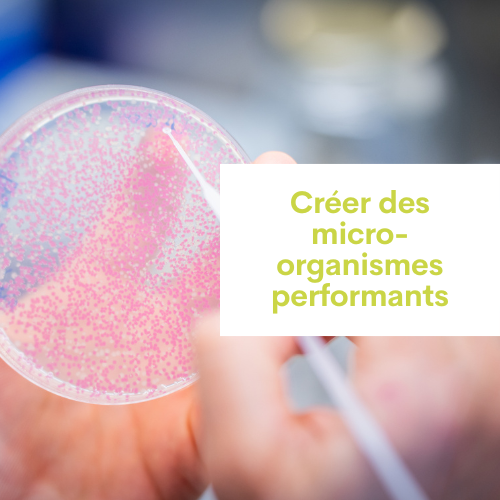

METASYS team
Integrated metabolism and dynamics of metabolic systems
Understanding to create, Creating to understand
The Metasys team is investigating and modifying microbial metabolism and its regulation with the aim of “understanding to create” and its complementary counterpart “creating to understand”- to deliver new fundamental knowledge on both natural and synthetic microorganisms while creating new industrially useful microorganisms. To do that the team integrates (i) a synthetic biology approach based on genome editing and adaptative laboratory evolution to engineer metabolic and/or regulatory systems in various microorganisms, (ii) a system-level approach based on in silico (reconstruction and modelling of metabolism) and experimental methods (transcriptomics, metabolomics, fluxomics) to understand and predict the behavior of the natural and synthetic strains, and (iii) a top-down systemic approach from the bioreactor to the microorganism based on kinetic analysis of the microbial behavior to decipher metabolic bottlenecks under intensive fermentation constraints (high titers, productivity and yield).
- ACIB, Austria – Petra Heidinger
- Autonomous University of Barcelona, Spain – Pau Ferrer
- BOKU, Austria – Diethard Mattanovisch
- Centre National d’Etudes Spatiales (CNES, Toulouse)
- EPFL, Switzerland – Sebastian Maerkl
- GeT-Biopuces Platform, Toulouse, France
- IIS, India – Balasubramanian Gopal
- INRAe MEDiS, France – Grégory Jubelin
- MaIAGE-INRAE, France – Pierre Nicolas
- Metatoul Platform, Toulouse, France
- NUS, Singapore – Chueh Loo Poh
- RWTH Aachen, Germany – Lars Blank and Lars Lauterbach
- TU Graz, Austria – Robert Kourist
- Toulouse White Biotechnology, Toulouse, France
- University Gröningen, Netherlands – Sandy Schmidt
- University of Kent, UK – Martin Warren
- University of Kiel, Germany – Andreas Tholey
- Integrative Electron Microscope Platform (METi), Toulouse, France
- Dorian Gregnanin – Projet METHYLO
- Thomas Gosselin-Monplaisir – Projet COCA-COLI
- Itzel Castro-Gonzalez – Projet ConCO2rde
- Javier Garcia-Navarro – Projet ConCO2rde
- Bastien Marie – Projet TETAX
- Jéremy Le Reun – Projet LIPIDS